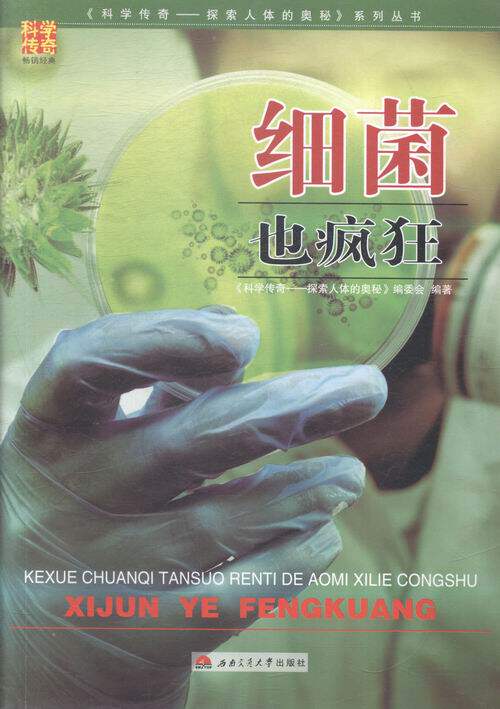

Подлинные бактерии также сумасшедшие «Легенда науки и Mdash; & Mdash; Исследуйте тайну человеческого тела» Биологические книги мира 9787564335083
Цена: 520руб. (¥24.6)
Артикул: 608078366936
Вес товара: ~0.7 кг. Указан усредненный вес, который может отличаться от фактического. Не включен в цену, оплачивается при получении.
Продавец:读买天下图书专营店
Рейтинг:

Всего отзывов:0
Положительных:0
Добавить в корзину
- Информация о товаре
- Фотографии
